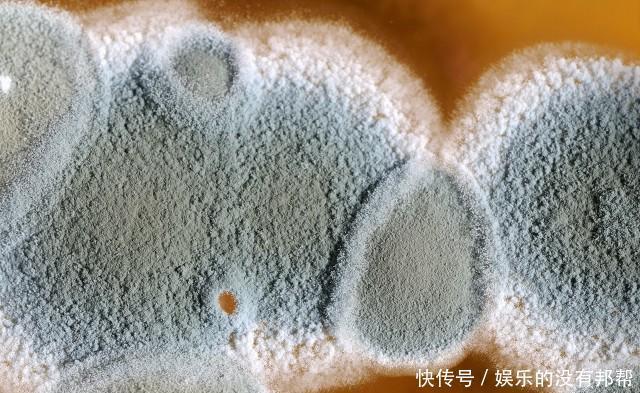
尘螨|隐藏在家里的过敏原,也会让孩子出现过敏反应:咳嗽、打喷嚏

尘螨|隐藏在家里的过敏原,也会让孩子出现过敏反应:咳嗽、打喷嚏
文/王笑雪
前段时间五一放假,我们带孩子回到爷爷奶奶的老家,没成想回去刚待了两天,儿子就开始咳嗽起来,刚开始我以为他感冒了,可是他又没有别的症状。
以往孩子咳嗽时,赶紧让他喝水还能压一压,这次喝水也不行,根本止不住,而且越咳越厉害。

文章插图
【 尘螨|隐藏在家里的过敏原,也会让孩子出现过敏反应:咳嗽、打喷嚏】后来我就赶紧带孩子去医院,医生听了我们的描述后,怀疑是过敏反应,就给孩子做了过敏原检测和肺功能检查,结果谁也没有想到,孩子出现的咳嗽确实属于过敏反应,而导致孩子过敏的源头就是尘螨。
回想起公婆家的老房子,平时公公也很少去住,这次是因为我们带着孩子回来,所以临时搬回了老房子,因为有个大院子,想着可以让娃尽情的自由奔跑玩耍,可能平时疏忽打扫卫生,导致它成为了致使孩子咳嗽的“罪魁祸首”。

文章插图
生活中,经常也会遇到妈妈们说,孩子没有吃什么容易过敏的食物,怎么总是出现过敏反应呢,咳嗽、喷嚏打不停,这是怎么回事呢?
隐藏在家里的过敏原
1、肉眼看不见的尘螨
我给儿子买过一本书叫做《微观世界》,里面有一节内容就讲到了尘螨,看着放大后尘螨的样子,难以想象它们其实就和我们共同生活在一起,尤其是床上用品更是尘螨喜欢待的地方,它们以人体以及动物脱落的皮屑为食物,是潜在的室内过敏原,也是诱发哮喘的主要原因。

文章插图
怎么清除尘螨呢?
由于尘螨怕干、怕高温,所以要经常把被子抱到太阳底下暴晒,同时用力拍打被褥及枕头。
另外夏天到了,家里的空调也要再次启用了,在使用之前,也要注意先清洗空调的滤网,而且还要定期更换滤网,让尘螨无处可躲。
2、潮湿环境下的霉菌
霉菌也是一种过敏原,所以对霉菌过敏的人就不太适合生活在南方了,尤其是遇到梅雨季节,潮湿、通气不良的环境可是霉菌生长的“风水宝地”。
之前有科普说室内加湿器也不能随便用,就是因为霉菌能够在制冷、加热及湿化设备中生长,所以加湿器使用不当反而会促进霉菌的生长。
文章插图
其实无论孩子是否对霉菌过敏,家里都应该注意防止霉菌滋生,例如室内经常通风,尤其是浴室内、卫生间、橱柜、厨房等;家里洗衣机也要定期清理;儿童房尽量选向阳的房间等。
3、繁殖能力旺盛的蟑螂
我们都知道蟑螂有旺盛的繁殖能力和顽强的生命力,可它也是一种过敏原,有研究称,“蟑螂是国内诱发哮喘的过敏原之一,仅次于尘螨。”
在生活中,要经常打扫卫生,做到家里干净整洁,不给蟑螂生存的机会,例如家里不要堆放捡来的纸箱、空瓶子等(尤其是老房子),每天及时清理厨余垃圾。如果家中不慎出现蟑螂,更要利用一切方法消灭蟑螂。

文章插图
之前有听同事讲过,有一次她去别的城市出差,住的酒店里有蟑螂(她事先不知道),结果把一只蟑螂装在行李箱里带回家了!所以她提醒我们外出出差时,自己的行李箱不用了要及时扣上,可别就那么敞着口。
4、家养的可爱宠物
家养的可爱宠物,例如小狗小猫等都可能是导致孩子过敏的过敏原,因为它们会通过唾液、尿液、粪便和皮屑等释放过敏原,它可能通过空气传播,也可能在打扫卫生时引起飘散,悬浮在空气中,导致孩子出现咳嗽、打喷嚏等过敏反应。所以打扫卫生时,尽量避开孩子在家的时候。
- 春节将至,带孩子回老家过年,这些安全隐患要早识破避免娃受伤
- 疫苗|儿童感染奥密克戎,症状更隐匿!一张图区分流感还是奥密克戎
- 猫咖|四岁孩子在猫咖店被咬伤 “网红”猫咖店隐患真不少
- 家长|幼儿园教师工资虽不多,但除了周末双休,还有很多“隐藏”福利
- 卡琳·西蒙妮|发现孩子的天赋重要,付出努力更重要,藏在童书里的大智慧
- 产后护士追着问的这个隐私问题,产妇一定要正面回答,别觉得害羞
- 新生儿出生后100天,新手妈妈要警惕的健康隐患,太全了
- 什么|藏在袁大娘心底的秘密,这么多年,她一直觉得自己有愧于他
- 食物中隐藏的胎儿“致畸物”,孕妈妈能不碰就不碰
- 大脑|“高智商”宝宝的4大隐藏特征,中2条以上,助力他赢在起跑线上